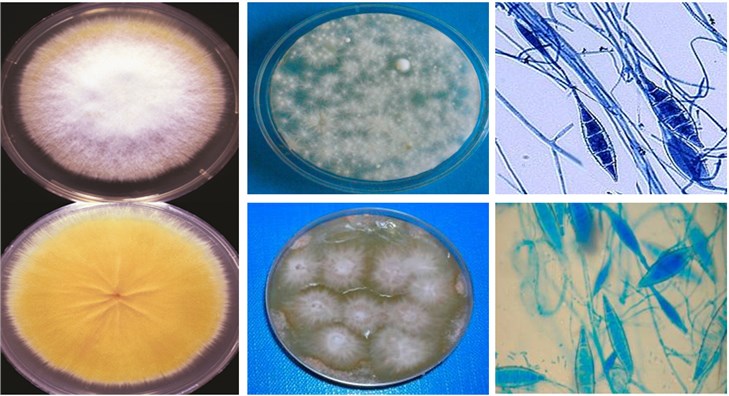

Microsporum canis
As a leading company in the field of biological research and drug discovery, Creative Biolabs has gained a wealth of good reputation for successfully completed numerous challenges in antifungal drug discovery. Based on our advanced technology platform and experienced scientists, we are able to provide a series of antifungal drug discovery services against various fungal diseases and related fungi. Here, we describe a pathogenic fungus Microsporum canis that can cause dermatophytosis.
Introduction
As a part of dermatophytes, Microsporum canis (M. canis) is a pathogenic, asexual fungus, for which cats and dogs are recognized as the natural hosts. It belongs to genus Microsporum, family Arthrodermataceae, order Onygenales, class Eurotiomycetes, and division Ascomycota.
Distribution and Transmission
The fungus has a worldwide distribution, particularly in humid, warm climates like Europe, the eastern Mediterranean, and South America. M. canis is the most prevalent zoophilic dermatophyte causing humans tinea capitis and tinea corporis, which are highly contagious and readily transmitted between animals and humans via direct physical contact or through indirect contact with fungus-contaminated materials.
Mycology of M. canis
- Macroscopically, M. canis is a white to a yellowish colony with a coarsely fluffy, velvety/powdery texture approximately 3 to 9 cm in diameter. The reverse side of the growth medium ranges from being burnt orange to yellow, which due to the metabolites secreted by the fungus and on what strain of Microsporum canis may be growing.
- Microscopically, M. canis reproduces by means of two conidial form multi-celled macroconidia and single-celled microconidia. The asexual propagation of the fungus is produced through forming asymmetrical, spherically shaped macroconidia. The macroconidia are fusiform, verrucose with thick and coarsely roughened cell walls. Each macroconidium is typically divided into six or more compartments separated by broad cross-walls. M. canis also produces a few pyriform to clavate microconidia.
Fig. 1 Macroscopic and microscopic phenotypes of M. canis.1
Fig. 1 Macroscopic and microscopic phenotypes of M. canis.1
Pathogenesis of M. canis
M. canis mainly causes dermatophytosis in cats and dogs. And infected animals and asexual spores contaminated objects are common sources for human infection. Spores are very resistant, attach to the skin and germinate producing hyphae, which will then grow in the dead, superficial layers of the skin, hair or nails.
Similar to other fungal dermatophytes, M. canis also secretes keratinolytic protease and gains energy from keratin in nails, hair, and skin. This organism degrades keratin into easily assimilable metabolites that can be utilized as the nutrition and causes some damages to the skin and hair follicle. The fungal invasion on the skin triggers an anaphylactic reaction, as a result, skin is becoming inflamed and the fungus is moving away from the site to normal skin. Thus, the symptom that circular lesion with healing at the center and inflammation at the edge is formed. Differently, M. canis causes an ectothrix-type infection where the fungus envelopes the exterior of the hair shaft without the formation of internal spores when attacks in the hair. The colonization of the fungus results in characteristic round or oval non-inflammatory lesions and unsheathed hair shaft.
If you are interested in the fungal disease-related services, please contact us for more detailed information.
Reference
- Pasquetti, M.; et al. Infection by Microsporum canis in Paediatric Patients: A Veterinary Perspective. Veterinary Sciences. 2017, 4(3): 46. Distributed under Open Access license CC BY 4.0, without modification.
For Research Use Only.
